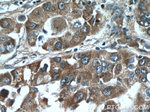
RSRC1 Antibody in Immunohistochemistry (Paraffin) (IHC (P))

Search
Proteintech
RSRC1 Polyclonal Antibody
{{$productOrderCtrl.translations['antibody.pdp.commerceCard.promotion.promotions']}}
{{$productOrderCtrl.translations['antibody.pdp.commerceCard.promotion.viewpromo']}}
{{$productOrderCtrl.translations['antibody.pdp.commerceCard.promotion.promocode']}}: {{promo.promoCode}} {{promo.promoTitle}} {{promo.promoDescription}}. {{$productOrderCtrl.translations['antibody.pdp.commerceCard.promotion.learnmore']}}
产品信息
23826-1-AP
种属反应
宿主/亚型
分类
类型
抗原
偶联物
形式
浓度
规格
纯化类型
保存液
内含物
保存条件
运输条件
产品详细信息
Immunogen sequence: AGLEHLPPA EQAKARLQLV LEAAAKADEA LKAKERNEEE AKRRKEEDQA TLVEQVKRVK EIEAIESDSF VQQTFRSSKE VKKSVEPSEV KQATSTSGPA SAVADPPSTE KEIDPTSIPT AIKYQDDNSL AHPNLFIEKA DAEEKWFKRL IALRQERLMG SPVA (172-334 aa encoded by B C006982)
靶标信息
RSRC1 is a gene that encodes a protein belonging to the serine and arginine rich-related protein family. This protein plays a crucial role in both constitutive and alternative mRNA splicing. Research suggests that this gene may be linked to schizophrenia, and a pseudogene of RSRC1 is present on chromosome 9. Alternative splicing of RSRC1 leads to the formation of multiple transcript variants that encode distinct isoforms. Additionally, RSRC1 has been associated with various disorders, including Autosomal Recessive Non-Syndromic Intellectual Disability and Intellectual Developmental Disorder, Autosomal Recessive 70.
仅用于科研。不用于诊断过程。未经明确授权不得转售。
生物信息学
蛋白别名: arginine/serine-rich coiled-coil 1; Arginine/serine-rich coiled-coil protein 1; Serine/Arginine-related protein 53; splicing factor, arginine/serine-rich 21; SRrp53; unnamed protein product
基因别名: BM-011; MRT70; RSRC1; SFRS21; SRRP53
UniProt ID: (Human) Q96IZ7
Entrez Gene ID: (Human) 51319